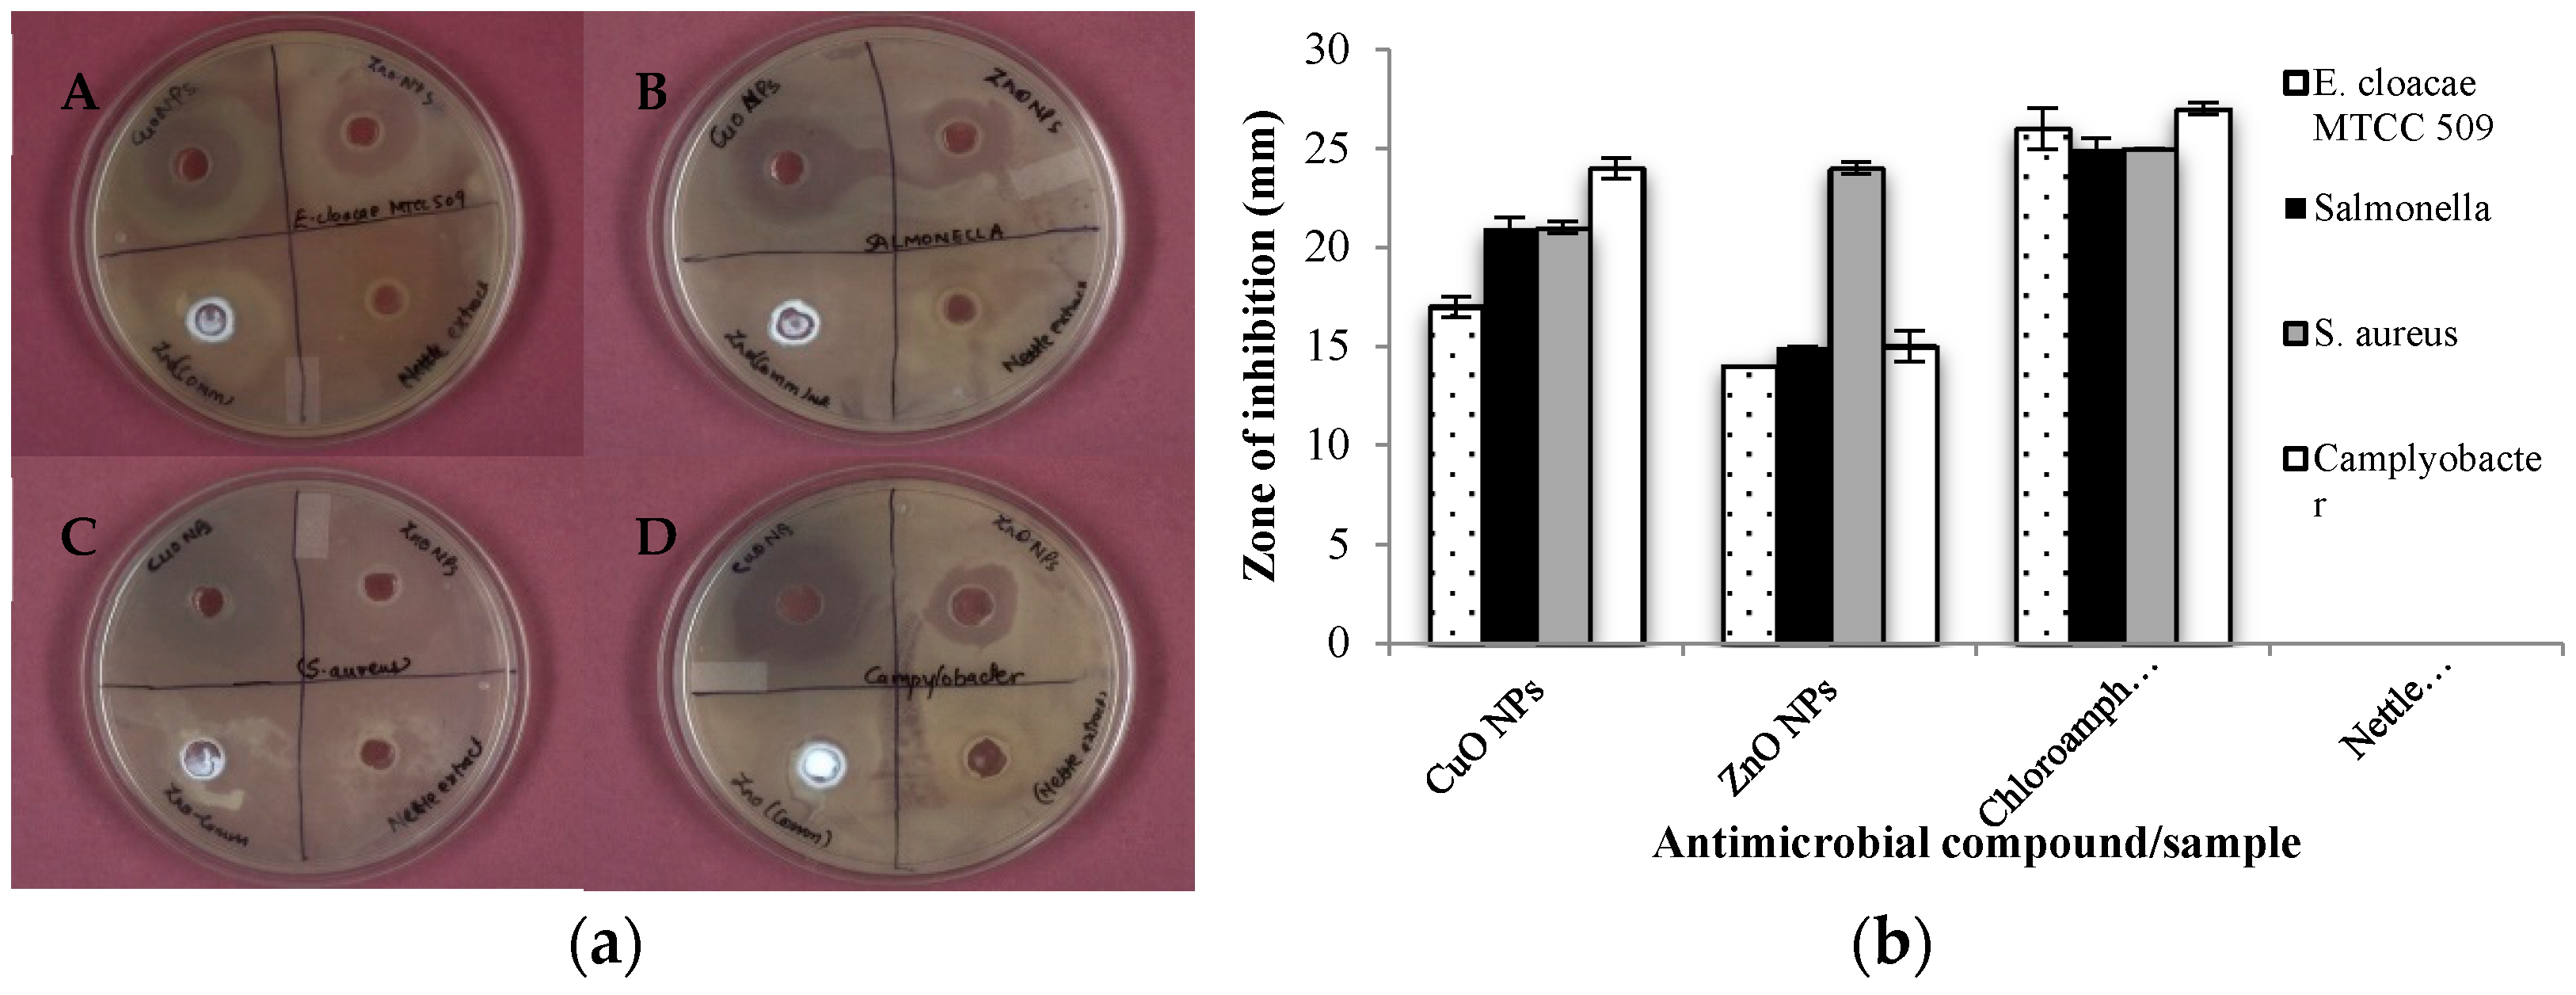
Biomolecules 11 00224 g003 Biomolecules 11 00224 g003
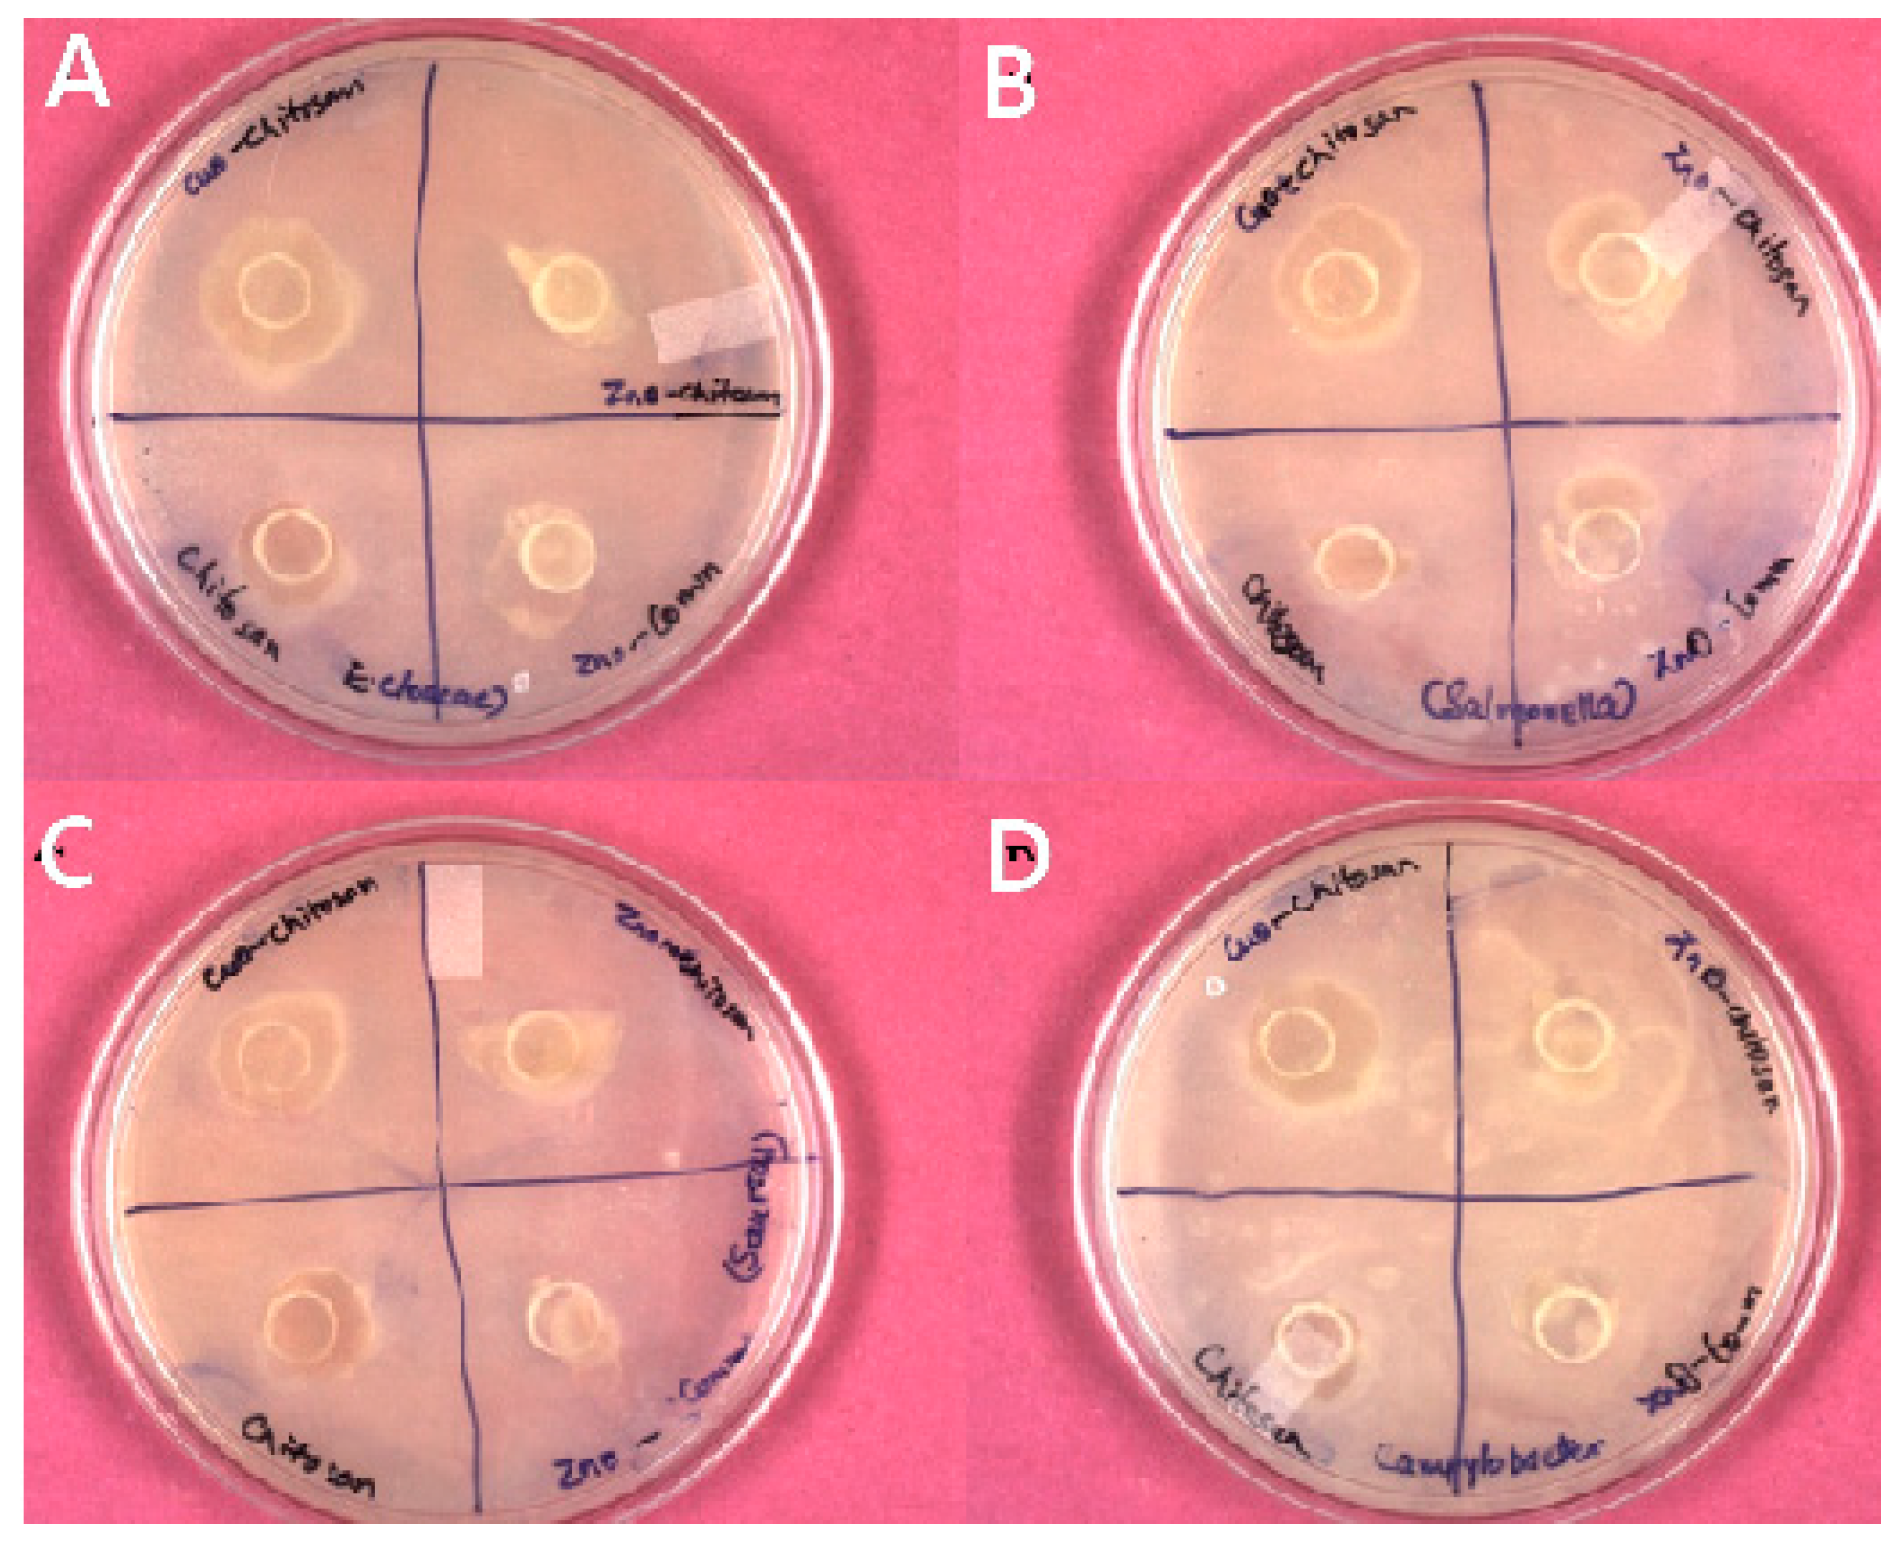
Biomolecules 11 00224 g004 Biomolecules 11 00224 g004

Nettle-Leaf Extract Derived ZnO/CuO Nanoparticle-Biopolymer-Based Antioxidant and Antimicrobial Nanocomposite Packaging Films and Their Impact on Extending the Post-Harvest Shelf Life of Guava Fruit
Abstract
1. Introduction
2. Materials and Methods
2.1. Materials
2.1.1. Chemicals
2.1.2. Microbial Cultures
2.1.3. Guava Fruits
2.2. Methods
2.2.1. Biosynthesis of Nanoparticles
2.2.2. Nanoparticle Characterization
2.2.3. 2,2-Diphenyl-1-Picryl-Hydrazyl (DPPH) Radical Scavenging Activity (RSA)
2.2.4. Antimicrobial Activity (AMA) of Synthesized Nanoparticles
2.2.5. Fabrication of Chitosan Nanocomposite Films
2.2.6. Antimicrobial Activity of Chitosan Nanocomposite Films
2.2.7. Physical Characterization of Films
Film Thickness
Surface Color Measurement of Films
Transparency
Film Moisture
Water Holding Capacity
Film Solubility
2.2.8. Chemical Structure Characterization of Prepared Films
SEM and SEM-EDS Analysis of the Films
Antioxidant Properties of Prepared Chitosan Nanocomposite Films
2.2.9. Physiological, Biochemical, and Microbiological Characterization of Guava Fruits
Weight Loss
Fruit Firmness
Soluble Solids
Titratable Acidity
Sensory Quality
Spoilage of Guava Fruits
3. Results
3.1. Nanoparticle Characterization
3.2. DPPH Radical Scavenging Activity (RSA)
3.3. Antimicrobial Activity of Synthesized NPs
3.4. AMA of Nanocomposite Films
3.5. Physical Properties of the Nanocomposite Films
3.5.1. Film Thickness
3.5.2. Optical Properties of the Nanocomposite Films
Surface Color
Film Transparency
Film Moisture
Water Holding Capacity
Film Solubility
3.6. Chemical Structure Characterization of the Nanocomposite Films
SEM and SEM-EDS of the Developed Films
3.7. Antioxidant Properties of Prepared Chitosan Nanocomposite Films
3.8. Physiological, Biochemical, and Microbiological Characterization of Guava Fruits
3.8.1. Weight Loss (%)
3.8.2. Fruit Firmness
3.8.3. Soluble Solids Content
3.8.4. Titratable Acidity
3.8.5. Sensory Quality
3.8.6. Fruit Spoilage
4. Discussion
5. Conclusions
Author Contributions
Funding
Institutional Review Board Statement
Informed Consent Statement
Data Availability Statement
Acknowledgments
Conflicts of Interest
References
- NHB. Area and Production of Horticultural Crops for 2017–2018. 2019. Available online: http://www.nhb.gov.in (accessed on 15 October 2020).
- Murmu, S.B.; Mishra, H.N. Post-harvest shelf-life of banana and guava: Mechanisms of common degradation problems and emerging counteracting strategies. Innov. Food Sci. Emerg. Technol. 2018, 49, 20–30. [Google Scholar] [CrossRef]
- Mangaraj, S.; Goswami, T.K. Measurement and modeling of respiration rate of Guava (cv. Baruipur) for modified atmosphere packaging. Int. J. Food Prop. 2011, 14, 609–628. [Google Scholar] [CrossRef]
- Silip, J.J.; Hajar, S.A. Optimization of storage temperature for maintaining quality of guava. Acta Hortic. 2007, 735, 535–546. [Google Scholar] [CrossRef]
- Ounkaew, A.; Kasemsiri, P.; Kamwilaisak, K.; Saengprachatanarug, K.; Mongkolthanaruk, W.; Souvanh, M.; Pongsa, U.; Chindaprasirt, P. Polyvinyl Alcohol (PVA)/Starch bioactive packaging film enriched with antioxidants from spent coffee ground and citric acid. J. Polym. Environ. 2018, 26, 3762–3772. [Google Scholar] [CrossRef]
- De Morais Lima, M.; Bianchini, D.; Guerra Dias, A.; Da Rosa Zavareze, E.; Prentice, C.; Silveira Moreira, A. Biodegradable films based on chitosan, xanthan gum, and fish protein hydrolysate. J. Appl. Polym. Sci. 2017, 134, 1–9. [Google Scholar] [CrossRef]
- Raigond, P.; Sood, A.; Kalia, A.; Joshi, A.; Kaundal, B.; Raigond, B.; Dutt, S.; Singh, B.; Chakrabarti, S.K. Antimicrobial activity of potato starch-based active biodegradable nanocomposite films. Potato Res. 2019, 62, 69–83. [Google Scholar] [CrossRef]
- Kaur, M.; Kalia, A.; Thakur, A. Effect of biodegradable chitosan-rice starch nanocomposite films on post-harvest quality of stored peach fruit. Starch 2017, 68. [Google Scholar] [CrossRef]
- Sousa, G.M.; Yamashita, F.; Soares-Júnior, M.S. Application of biodegradable films made from rice flour, poly (butylene adipate-co-terphthalate), glycerol and potassium sorbate in the preservation of fresh food pastas. LWT-Food Sci. Technol. 2015, 65, 39–45. [Google Scholar] [CrossRef]
- Henritte, M.C. Nanocomposites for food packaging applications. Food Res. Int. 2009, 42, 1240–1253. [Google Scholar]
- Xu, X.Y.; Kim, K.M.; Hanna, M.A.; Nag, D. Chitosan-starch composite film: Preparation and characterization. Ind. Crops Prod. 2005, 21, 185–192. [Google Scholar] [CrossRef]
- Priyadarshi, R.; Rhim, J.W. Chitosan-based biodegradable functional films for food packaging applications. Innov. Food Sci. Emerg. Technol. 2020, 62. [Google Scholar] [CrossRef]
- Amato, A.; Migneco, L.M.; Martinelli, A.; Pietrelli, L.; Piozzi, A.; Francolini, I. Antimicrobial activity of catechol functionalized-chitosan versus Staphylococcus epidermidis. Carbohydr. Polym. 2018, 179, 273–281. [Google Scholar] [CrossRef]
- Cuzzucoli Crucitti, V.; Migneco, L.M.; Piozzi, A.; Taresco, V.; Garnett, M.; Argent, R.H.; Francolini, I. Intermolecular interaction and solid state characterization of abietic acid/chitosan solid dispersions possessing antimicrobial and antioxidant properties. Eur. J. Pharm. Biopharm. 2018, 125, 114–123. [Google Scholar] [CrossRef] [PubMed]
- Hu, Q.; Fang, Y.; Yang, Y.; Ma, N.; Zhao, L. Effect of nanocomposite-based packaging on postharvest quality of ethylene-treated kiwifruit (Actinidia deliciosa) during cold storage. Food Res. Int. 2011, 44, 1589–1596. [Google Scholar] [CrossRef]
- Kaur, M.; Kalia, A. Role of salt precursors for the synthesis of zinc oxide nanoparticles in imparting variable antimicrobial activity. J. Appl. Nat. Sci. 2016, 8, 1039–1048. [Google Scholar] [CrossRef]
- Kalia, A.; Kaur, J.; Kaur, A.; Singh, N. Antimycotic activity of biogenically synthesized metal and metal oxide nanoparticles against plant pathogenic fungus Fusarium moniliforme (F. fujikuroi). Indian J. Exp. Biol. 2020, 58, 263–270. [Google Scholar]
- Kalia, A.; Manchanda, P.; Bhardwaj, S.; Singh, G. Biosynthesized silver nanoparticles from aqueous extracts of sweet lime fruit and callus tissues possess variable antioxidant and antimicrobial potentials. Inorg. Nanometal Chem. 2020, 50, 1053–1062. [Google Scholar] [CrossRef]
- Iravani, S. Green synthesis of metal nanoparticles using plants. Green Chem. 2011, 13, 2638–2650. [Google Scholar] [CrossRef]
- Viktorova, J.; Jandova, Z.; Madlenakova, M.; Prouzova, P.; Bartunek, V.; Vrchotova, B.; Lovecka, P.; Musilova, L.; Macek, T. Native phytoremediation potential of Urtica dioica for removal of PCBs and heavy metals can be improved by genetic manipulations using constitutive CaMV 35S promoter. PLoS ONE 2017, 12, e0187053. [Google Scholar] [CrossRef]
- Kregiel, D.; Pawlikowska, E.; Antolak, H. Urtica spp.: Ordinary plants with extraordinary properties. Molecules 2018, 23, 1664. [Google Scholar] [CrossRef]
- Keskin-Sasic, I.; Tahirovic, I.; Topcagic, A.; Klepo, L.; Salihovic, M.; Ibragic, S.; Toromanovic, J.; Ajanovic, A.; Velispahic, E. Total phenolic content and antioxidant capacity of fruit juices. Bull. Chem. Technol. Bosnia Herzeg. 2012, 39, 25–28. [Google Scholar]
- Ebrahiminezhad, A.; Zare-Hoseinabadi, A.; Berenjian, A.; Ghasemi, Y. Synthesis and characterization of zero-valent iron nanoparticles using stinging nettle (Urtica dioica) leaf extract. Green Process. Synth. 2016, 6, 469–475. [Google Scholar] [CrossRef]
- Kaur, G.; Kalia, A.; Sodhi, H.S. Selenium biofortification of Pleurotus species and its effect on yield, phytochemical profiles, and protein chemistry of fruiting bodies. J. Food Biochem. 2018, 42. [Google Scholar] [CrossRef]
- Boyle, V.J.; Fancher, M.E.; Ross, R.W.; Rapid, J.R. Modified Kirby-Bauer susceptibility test with single, high-concentration antimicrobial disks. Antimicrob. Agents Chemother. 1973, 3, 418–424. [Google Scholar] [CrossRef] [PubMed]
- Siripatrawan, U.; Harte, B.R. Physical properties antioxidant activity of an active film from chitosan incorporated with green tea extract. Food Hydrocoll. 2010, 24, 770–775. [Google Scholar] [CrossRef]
- Zheng, L.; Zhao, M.; Xiao, C.; Zhao, Q.; Su, G. Practical problems when using ABTS assay to assess the radical-scavenging activity of peptides: Importance of controlling reaction pH and time. Food Chem. 2016, 192, 288–294. [Google Scholar] [CrossRef]
- William, H. Official Methods of Analysis, Association of Official Analytical Chemists; AOAC Intl.: Gaithersburg, MD, USA, 2000. [Google Scholar]
- Amerine, M.A.; Pangborn, R.M.; Roessler, E.B. Principles of Sensory Evaluation of Food, 1st ed.; Academic Press: London, UK, 1965; pp. 494–518. [Google Scholar]
- Throndsen, J. The dilution-culture method. In Phytoplankton manual Monographs on Oceanographic Methodology; Sournia, A., Ed.; UNESCO: Paris, France, 1978; pp. 218–244. [Google Scholar]
- Naika, H.R.; Lingaraju, K.; Manjunath, K.; Kumar, D.; Nagaraju, G.; Suresh, D.; Nagabhushana, H. Green synthesis of CuO nanoparticles using Gloriosa superb L. extract and their antibacterial activity. J. Taibah Univ. Sci. 2015, 9, 7–12. [Google Scholar] [CrossRef]
- Santhoshkumar, J.; Kumar, S.V.; Kumar, S.R. Synthesis of zinc oxide nanoparticles using plant leaf extract against urinary tract infection pathogen. Resour.-Effic. Technol. 2017, 3, 459–465. [Google Scholar] [CrossRef]
- Jayakumarai, G.; Gokulpriya, C.; Sudhapriya, R.; Sharmila, G.; Muthukumaran, C. Phytofabrication and characterization of monodisperse copper oxide nanoparticles using Albizia lebbeck leaf extract. Appl. Nanosci. 2015, 5, 1075–1081. [Google Scholar] [CrossRef]
- Akbarian, M.; Mahjoub, S.; Elahi, S.M.; Zabihi, E.; Tashakkorian, H. Urtica dioica L. extracts as a green catalyst for the biosynthesis of zinc oxide nanoparticles: Characterization and cytotoxic effects on fibroblast and MCF-7 cell lines. New J. Chem. 2018, 42, 5822–5833. [Google Scholar] [CrossRef]
- Kumari, J.; Baunthiyal, M.; Singh, A. Characterization of silver nanoparticles synthesized using Urtica dioica Linn. leaves and their synergistic effects with antibiotics. J. Radiat. Res. Appl. Sci. 2016, 9, 217–227. [Google Scholar]
- Al-Tameme, H.J.; Hadi, M.Y.; Hameed, I.H. Phytochemical analysis of Urtica dioica leaves by Fourier-transform infrared spectroscopy and Gas chromatography-Mass spectrometry. J. Pharmacogn. Phytother. 2015, 7, 238–252. [Google Scholar]
- Prakash, P.; Gnanaprakasam, P.; Emmanuel, R.; Arokiyaraj, S.; Saravanan, M. Green synthesis of silver nanoparticles from leaf extract of Mimusops elengi, Linn. for enhanced antibacterial activity against multi drug resistant clinical isolates. Colloids Surf. B 2013, 108, 255–259. [Google Scholar] [CrossRef] [PubMed]
- Sorbium, M.; Mehr, E.S.; Ramazani, A.; Fardood, S.T. Green synthesis of zinc oxide and copper oxide nanoparticles using aqueous extract of Oak fruit hull (Jaft) and comparing their photocatalytic degradation of basic violet 3. Int. J. Environ. Res. 2018, 12, 29–37. [Google Scholar] [CrossRef]
- Geetha, M.S.; Nagabhushana, H.; Shivanajaiah, H.N. Green mediated synthesis and characterization of ZnO nanoparticles using Euphorbia jatropa Latex as reducing agent. J. Sci. Adv. Mater. Devices 2016, 1, 301–310. [Google Scholar] [CrossRef]
- Matinise, N.; Fuku, X.G.; Kaviyarasu, K.; Mayedwa, N.; Maaza, M. ZnO nanoparticles via Moringa oleifera green synthesis: Physical properties and mechanism of formation. Appl. Surf. Sci. 2017, 406, 339–347. [Google Scholar] [CrossRef]
- Knezevic, V.; Pezo, L.L.; Loncar, B.L.; Filipovic, V.S.; Nicetin, M.R.; Gorjanovic, S.Z.; Suput, D. Antioxidant capacity of nettle leaves during osmotic treatment. Period. Polytech. Chem. Eng. 2019, 63, 491–498. [Google Scholar]
- Abdel-Aziz, M.S.; Shaheen, M.S.; El-Nekeety, A.A.; Abdel-Wahhab, M.A. Antioxidant and antibacterial activity of silver nanoparticles biosynthesized using Chenopodium murale leaf extract. J. Saudi Chem. Soc. 2013, 18, 356–363. [Google Scholar] [CrossRef]
- Muthuvel, A.; Jothibas, M.; Manoharan, C. Effect of chemically synthesis compared to biosynthesized ZnO-NPs using Solanum nigrum leaf extract and their photocatalytic, antibacterial and in-vitro antioxidant activity. J. Environ. Chem. Eng. 2020, 8. [Google Scholar] [CrossRef]
- Altikatoglu, M.; Attar, A.; Erci, F.; Cristache, C.M.; Isildak, I. Green synthesis of copper oxide nanoparticles using Ocimum basilicum extract and their antibacterial activity. Fresenius Environ. Bull. 2017, 26, 7832–7837. [Google Scholar]
- Salmen, S.H.; Sulaiman, A.A. Silver nanoparticles synthesized biogenically from Aloe fleurentiniorum extract: Characterization and antibacterial activity. Green Chem. Lett. Rev. 2020, 13, 1–5. [Google Scholar] [CrossRef]
- Kadam, D.; Momin, B.; Palamthodi, S.; Lele, S.S. Physicochemical and functional properties of chitosan-based nano-composite films incorporated with biogenic silver nanoparticles. Carbohydr. Polym. 2019, 211, 124–132. [Google Scholar] [CrossRef] [PubMed]
- Mathew, S.; Snigdha, S.; Mathew, J.; Radhakrishnan, E.K. Biodegradable and active nanocomposite pouches reinforced with silver nanoparticles for improved packaging of chicken sausages. Food Packag. Shelf Life 2019, 19, 155–166. [Google Scholar] [CrossRef]
- Salari, M.; Khiabani, M.S.; Mokarram, R.R.; Ghanbarzadeh, B.; Kafil, H.S. Development and evaluation of chitosan based active nanocomposite films containing bacterial cellulose nanocrystals and silver nanoparticles. Food Hydrocoll. 2018, 84, 414–423. [Google Scholar] [CrossRef]
- Kumar, S.; Mudai, A.; Roy, B.; Basumatary, I.B.; Mukherjee, A.; Dutta, J. Biodegradable hybrid nanocomposite of chitosan/gelatin and green synthesized zinc oxide nanoparticles for food packaging. Foods 2020, 9, 1143. [Google Scholar] [CrossRef]
- Xiong, H.; Tang, S.; Tang, H.; Zou, P. The structure and properties of a starch-based biodegradable film. Carbohydr. Polym. 2008, 71, 263–268. [Google Scholar] [CrossRef]
- López-Mata, M.A.; Ruiz-Cruz, S.; Silva-Beltrán, N.P.; Ornelas-Paz, J.J.; Ocaño-Higuera, V.M.; Rodríguez-Félix, F.; Cira-Chávez, L.A.; Del-Toro-Sánchez, C.L.; Shirai, K. Physicochemical and antioxidant properties of chitosan films incorporated with cinnamon oil. Int. J. Polym. Sci. 2015, 2015, 974506. [Google Scholar] [CrossRef]
- López-Mata, M.A.; Ruiz-Cruz, S.; Ornelas-Paz, J.J.; Del Toro-Sánchez, C.L.; Márquez-Ríos, E.; Silva-Beltrán, N.S.; Cira-Chávez, L.A.; Burruel-Ibarra, S.L. Mechanical, barrier and antioxidant properties of chitosan films incorporating cinnamaldehyde. J. Polym. Environ. 2018, 26, 452–461. [Google Scholar] [CrossRef]
- Li, W.; Zheng, K.; Chen, H.; Feng, S.; Wang, W.; Qin, C. Influence of nano titanium dioxide and clove oil on chitosan-starch film characteristics. Polymers 2019, 11, 1418. [Google Scholar] [CrossRef] [PubMed]
- Vishwasrao, C.; Ananthanarayan, L. Postharvest shelf-life extension of pink guavas (Psidium guajava L.) using HPMC-based edible surface coatings. J. Food Sci. Technol. 2016, 53, 1966–1974. [Google Scholar] [CrossRef]
- Batista Silva, W.; Cosme Silva, G.M.; Santana, D.B.; Salvador, A.R.; Medeiros, D.B.; Belghith, I.; da Silva, N.M.; Cordeiro, M.H.M.; Misobutsi, G.P. Chitosan delays ripening and ROS production in guava (Psidium guajava L.) fruit. Food Chem. 2018, 242, 232–238. [Google Scholar] [CrossRef]
- Xiao, X.Y.; Kuang, J.F.; Qi, X.N.; Ye, Y.J.; Wu, Z.X.; Chen, J.Y.; Lu, W.J. A comprehensive investigation of starch degradation process and identification of a transcriptional activator MabHLH6 during banana fruit ripening. Plant Biotechnol. J. 2018, 16, 151–164. [Google Scholar] [CrossRef]
- Zhao, L.; Xiao, H.; Zheng, H.; Hu, Q. Effect of nano-packing on preservation quality of Chinese Jujube. Food Chem. 2009, 114, 547–552. [Google Scholar]
- Pu, H.; Liu, D.; Wang, L.; Sun, D.W. Soluble solids content and pH prediction and maturity discrimination of lychee fruits using visible and near infrared hyperspectral imaging. Food Anal. Methods 2016, 9, 235–244. [Google Scholar] [CrossRef]
- Wang, D.; Ma, Q.; Belwal, T.; Li, D.; Li, W.; Li, L.; Luo, Z. High carbon dioxide treatment modulates sugar metabolism and maintains the quality of fresh-cut pear fruit. Molecules 2020, 25, 4261. [Google Scholar] [CrossRef]
- Saraiva, L.D.A.; Florence Polegato, C.; Renata, S.; Hassimotto, N.M.A.; Eduardo, P.; Marc, C.; Cordenunsi, B.R. Black leaf streak disease affects starch metabolism in banana fruit. J. Agric. Food Chem. 2013, 61, 5582–5589. [Google Scholar] [CrossRef]
- Etienne, A.; Génard, M.; Lobit, P.; Mbeguié-A-Mbéguié, D.; Bugaud, C. What controls fleshy fruit acidity? A review of malate and citrate accumulation in fruit cells. J. Exp. Bot. 2013, 64, 1451–1469. [Google Scholar] [CrossRef] [PubMed]
- Ladaniya, M.S. Physico-chemical, respiratory and fungicide residue changes in wax coated mandarin fruit stored at chilling temperature with intermittent warming. J. Food Sci. Technol. 2011, 48, 150–158. [Google Scholar] [CrossRef] [PubMed]
- Kalia, A.; Abd-Elsalam, K.A.; Kuca, K. Zinc-based nanomaterials for diagnosis and management of plant diseases: Ecological safety and future prospects. J. Fungi 2020, 6, 222. [Google Scholar] [CrossRef] [PubMed]
- Li, W.; Li, L.; Cao, Y.; Lan, T.; Chen, H.; Qin, Y. Effects of PLA film incorporated with ZnO nanoparticle on the quality attributes of fresh-cut apple. Nanomaterials 2017, 7, 207. [Google Scholar] [CrossRef] [PubMed]
- Lavinia, M.; Hibaturrahman, S.N.; Harinata, H.; Wardana, A.A. Antimicrobial activity and application of nanocomposite coating from chitosan and ZnO nanoparticle to inhibit microbial growth on fresh-cut papaya. Food Res. 2019, 4, 307–311. [Google Scholar] [CrossRef]
- Kalia, A. Nano-revolution in beverage industry: Tailoring nano-engineering to consummate novel processing and packaging panacea. In Trends in Beverage Packaging; Grumezescu, A.M., Holban, A.M., Eds.; Volume 16: The Science of Beverages; Woodhead Publishing, Elsevier: Bucharest, Romania, 2019; pp. 163–190. [Google Scholar]

| Types of Films | L * | a * | b * | C * | h° | T (Opacity) |
|---|---|---|---|---|---|---|
| Control chitosan | 27.58 ± 0.82 a | −0.45 ± 0.07 b | 2.36 ± 0.18 b | 2.35 ± 0.07 b | 100.89 ± 0.33 c | 1.95 ± 0.03 b |
| Chitosan-CuO NPs | 25.55 ± 1.28 b | −0.88 ± 0.09 a | 1.23 ± 0.04 c | 1.54 ± 0.09 c | 125.47 ± 0.36 a | 2.01 ± 0.06 a |
| Chitosan-ZnO NPs | 27.48 ± 0.92 a | −0.76 ± 0.06 b | 3.33 ± 0.31 a | 3.37 ± 0.24 a | 103.68 ± 0.25 b | 1.70 ± 0.13 c |
| Film Type | MC (%) | WHC (%) | FS (%) |
|---|---|---|---|
| Chitosan control | 23.87 ± 1.86 a | 63.41 ± 2.28 a | 30.96± 2.11 a |
| Chitosan-ZnO NPs | 5.16 ± 1.62 b | 20.97 ± 1.69 b | 10.59 ± 1.33 b |
| Chitosan-CuO NPs | 6.15 ± 0.38 b | 26.09 ± 0.66 b | 13.58 ± 0.95 b |
| Firmness | SSC | TA | SQ | Weight Loss | Spoilage | |
|---|---|---|---|---|---|---|
| Firmness | 1 | |||||
| SSC | 0.197 | 1 | ||||
| TA | 0.597 ** | −0.193 | 1 | |||
| SQ | −0.035 | −0.104 | 0.262 | 1 | ||
| Weight loss | −0.848 ** | 0.084 | −0.721 ** | −0.378 ** | 1 | |
| Spoilage | −0.626 ** | 0.146 | −0.700 ** | −0.539 ** | 0.895 ** | 1 |
Publisher’s Note: MDPI stays neutral with regard to jurisdictional claims in published maps and institutional affiliations. |
© 2021 by the authors. Licensee MDPI, Basel, Switzerland. This article is an open access article distributed under the terms and conditions of the Creative Commons Attribution (CC BY) license (http://creativecommons.org/licenses/by/4.0/).
Share and Cite
Kalia, A.; Kaur, M.; Shami, A.; Jawandha, S.K.; Alghuthaymi, M.A.; Thakur, A.; Abd-Elsalam, K.A. Nettle-Leaf Extract Derived ZnO/CuO Nanoparticle-Biopolymer-Based Antioxidant and Antimicrobial Nanocomposite Packaging Films and Their Impact on Extending the Post-Harvest Shelf Life of Guava Fruit. Biomolecules 2021, 11, 224. https://doi.org/10.3390/biom11020224
Kalia A, Kaur M, Shami A, Jawandha SK, Alghuthaymi MA, Thakur A, Abd-Elsalam KA. Nettle-Leaf Extract Derived ZnO/CuO Nanoparticle-Biopolymer-Based Antioxidant and Antimicrobial Nanocomposite Packaging Films and Their Impact on Extending the Post-Harvest Shelf Life of Guava Fruit. Biomolecules. 2021; 11(2):224. https://doi.org/10.3390/biom11020224
Chicago/Turabian StyleKalia, Anu, Manpreet Kaur, Ashwag Shami, Sukhjit Kaur Jawandha, Mousa A. Alghuthaymi, Anirudh Thakur, and Kamel A. Abd-Elsalam. 2021. "Nettle-Leaf Extract Derived ZnO/CuO Nanoparticle-Biopolymer-Based Antioxidant and Antimicrobial Nanocomposite Packaging Films and Their Impact on Extending the Post-Harvest Shelf Life of Guava Fruit" Biomolecules 11, no. 2: 224. https://doi.org/10.3390/biom11020224
APA StyleKalia, A., Kaur, M., Shami, A., Jawandha, S. K., Alghuthaymi, M. A., Thakur, A., & Abd-Elsalam, K. A. (2021). Nettle-Leaf Extract Derived ZnO/CuO Nanoparticle-Biopolymer-Based Antioxidant and Antimicrobial Nanocomposite Packaging Films and Their Impact on Extending the Post-Harvest Shelf Life of Guava Fruit. Biomolecules, 11(2), 224. https://doi.org/10.3390/biom11020224

